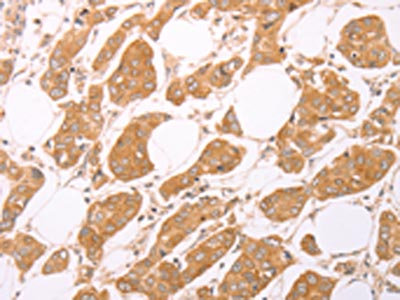

LEPR Antibody
-
中文名稱:LEPR兔多克隆抗體
-
貨號:CSB-PA145488
-
規格:¥1100
-
圖片:
-
其他:
產品詳情
-
Uniprot No.:
-
基因名:
-
別名:CD 295 antibody; CD295 antibody; CD295 antigen antibody; Db antibody; Fa antibody; HuB219 antibody; LEP R antibody; LEP-R antibody; LEPR antibody; LEPR_HUMAN antibody; LEPRD antibody; Leptin receptor antibody; Leptin receptor fatty antibody; Leptin receptor gene related protein antibody; Leptin receptor precursor antibody; Leptin receptor precursor antibody; OB R gene related protein antibody; OB receptor antibody; OB-R antibody; OB-RGRP antibody; obl antibody; Obr antibody
-
宿主:Rabbit
-
反應種屬:Human
-
免疫原:Synthetic peptide of Human LEPR
-
免疫原種屬:Homo sapiens (Human)
-
標記方式:Non-conjugated
-
抗體亞型:IgG
-
純化方式:Antigen affinity purification
-
濃度:It differs from different batches. Please contact us to confirm it.
-
保存緩沖液:-20°C, pH7.4 PBS, 0.05% NaN3, 40% Glycerol
-
產品提供形式:Liquid
-
應用范圍:ELISA,IHC
-
推薦稀釋比:
Application Recommended Dilution ELISA 1:2000-1:5000 IHC 1:25-1:100 -
Protocols:
-
儲存條件:Upon receipt, store at -20°C or -80°C. Avoid repeated freeze.
-
貨期:Basically, we can dispatch the products out in 1-3 working days after receiving your orders. Delivery time maybe differs from different purchasing way or location, please kindly consult your local distributors for specific delivery time.
-
用途:For Research Use Only. Not for use in diagnostic or therapeutic procedures.
相關產品
靶點詳情
-
功能:Receptor for hormone LEP/leptin (Probable). On ligand binding, mediates LEP central and peripheral effects through the activation of different signaling pathways such as JAK2/STAT3 and MAPK cascade/FOS. In the hypothalamus, LEP acts as an appetite-regulating factor that induces a decrease in food intake and an increase in energy consumption by inducing anorexinogenic factors and suppressing orexigenic neuropeptides, also regulates bone mass and secretion of hypothalamo-pituitary-adrenal hormones. In the periphery, increases basal metabolism, influences reproductive function, regulates pancreatic beta-cell function and insulin secretion, is pro-angiogenic and affects innate and adaptive immunity. Control of energy homeostasis and melanocortin production (stimulation of POMC and full repression of AgRP transcription) is mediated by STAT3 signaling, whereas distinct signals regulate NPY and the control of fertility, growth and glucose homeostasis. Involved in the regulation of counter-regulatory response to hypoglycemia by inhibiting neurons of the parabrachial nucleus. Has a specific effect on T lymphocyte responses, differentially regulating the proliferation of naive and memory T -ells. Leptin increases Th1 and suppresses Th2 cytokine production.; May transport LEP across the blood-brain barrier. Binds LEP and mediates LEP endocytosis. Does not induce phosphorylation of and activate STAT3.; Antagonizes Isoform A and isoform B-mediated LEP binding and endocytosis.
-
基因功能參考文獻:
- reveal that breast cancer stem cell (BCSC) in triple-negative breast cancer depend on the transcription regulator HN1L for the sustained activation of the LEPR-STAT3 pathway, which makes it a potentially important target for both prognosis and BCSC therapy. PMID: 29249663
- LEPR rs1137101 and PPARG-2 rs1801282 had weak and medium negative effects on zBMI, respectively, and may slightly protect against childhood obesity. PMID: 29679223
- Study demonstrates that the human LR undergoes regulated intramembrane proteolysis and that the released LR intracellular domain translocates to the mitochondria where it inhibits Parkin-dependent mitophagy. PMID: 29932990
- acetaminophen was associated with asthma similarly extent among males and females carrying two common alleles of LEPR polymorphisms.Among those carrying at least one copy of the minor allele of LEPR polymorphisms, the magnitude of association between acetaminophen use and asthma was pronounced among males but not among females PMID: 30231898
- this study shows that leptin receptor q223r polymorphism influences neutrophil mobilization after Clostridium difficile infection PMID: 29363668
- serum levels increased in systemic lupus erythematosus patients with metabolic syndrome and correlated with carotid intima media thickness values PMID: 29954279
- Results show that LEPR rs1137101 allele G was associated with reduced BMI and waist-to-hip ratio; however, it showed a marginal contribution to lower risk of obesity and MetS in obese patients. These finding suggest that LEPR genetic variant may be useful biomarker of cardiometabolic risk in obese patients. PMID: 28975585
- the multivariate analysis showed that only gene polymorphism (GG versus GA +AA) and tumor stage significantly affect survival. LEPR gene variants rs1137101 might be a candidate risk factor for renal cell carcinoma in Egypt. PMID: 29453609
- find for the first time that there is a significant association between leptin receptor rs1137101 polymorphism and susceptibility to NSTEMI. There is also statistically meaningful association between decrease in serum selenium and increase in serum copper levels with susceptibility to NSTEMI PMID: 29964004
- LEPR Lys109Arg (rs1137100) was associated with polycystic ovary syndrome susceptibility and genotype AA was deduced to be a protective factor for polycystic ovary syndrome PMID: 29749830
- No differences in the distribution of prevalence of alleles and LEPR gene Q223R (rs1137101) genotypes in the groups of female patients with the knee joint osteoarthritis of different radiographic stages have been revealed. PMID: 29602931
- Study shows that plasma soluble leptin receptor levels are independently associated with pancreatic beta-cell function, but not with insulin resistance, in patients with type 2 diabetes. PMID: 28294581
- The results suggest that LEPR rs1327118 may be associated with elevated blood pressure and HDL-C levels in women with type 2 diabetes mellitus (T2DM), and rs3806318 may be associated with T2DM and elevated blood pressure in men with T2DM. PMID: 29301582
- Study demonstrated that in all tested human normal prostate and prostate cancer cell lines (LNCaP, DU145, PC3, PrEC, PrSMC and PrSC) transcription variants 4, 5 and 6 of the leptin receptor were not expressed. Leptin receptor transcription variants 1, 2 and 3 showed differential expression, all of them present in the PC3, PrEC and PrSC cell lines. PMID: 29115533
- Skeletal muscle leptin receptors are up-regulated in response to severe energy deficit. PMID: 28729389
- The leptin receptor polymorphism seems to affect neuroendocrine regulation of energy balance among adolescents with obesity. PMID: 28801068
- Elevated serum leptin level could be a predictor for arterial stiffness in hypertension patients. PMID: 27450396
- Study found an association between LEPR expression and malignant behavior of upper tract urothelial carcinoma. High LEPR expression is independently associated with poor recurrence-free and progression-free survival. PMID: 28188048
- Leptin Receptor Gene Variant rs11804091 Is Associated with BMI and Insulin Resistance in Spanish Female Obese Children. PMID: 28771179
- We demonstrate that leptin stimulates the phosphorylation of STAT3 in LEPRb-transfected non-cancer stem cells (CSCs) compared with non-transfected non-CSCs. The increased expression of LEPRb and STAT3 activation recapitulated the phosphorylation status of STAT3 in CSCs. Our data demonstrate that LEPRb-induced STAT3 activation is essential for the induction and maintenance of triple-negative breast cancer CSCs. PMID: 28729467
- Homozygous LEPR Arg223 is associated with a 2-fold reduction in oral and oropharyngeal cancer risk; the presence of the Arg223 allele in tumors is associated with worse disease-free and disease-specific survival; low LEPR expression is an independent risk factor PMID: 26634459
- We conducted a meta-analysis of published literature to identify the correlation between leptin receptor gene polymorphisms and the risk of obstructive sleep apnea syndrome . The Gln223Arg polymorphisms in the Caucasian population and the Pro1019Pro polymorphisms in the Chinese population are risk factors for obstructive sleep apnea syndrome PMID: 28169194
- Our results indicate a possible contribution of CNVs in LEPR, NEGR1, ARHGEF4, and CPXCR1 and the intergenic regions 12q15c, 15q21.1a, and 22q11.21d to the development of obesity, particularly abdominal obesity in Mexican children. PMID: 28428959
- Bioinformatics analysis predicted that both missense SNPs were functionally neutral and benign. CONCLUSIONS: The present meta-analysis did not detect significant genetic associations between LEPR Q223R and K109R polymorphisms and T2D risk PMID: 29293570
- results demonstrate that leptin binding to and signalling through ObR is not required for efficient transport across human endothelial monolayers, indicating that ObR is not the primary leptin transporter at the human Blood Brain Barrier. PMID: 27037668
- We did not observe significant associations between polymorphisms of the leptin receptor gene (Q223R and K109R) and BP variation. PMID: 28077420
- LEPR polymorphisms contribute to the heterogeneities in BMI, LDL-C, and HDL-C responsiveness that are induced by a HC/LF diet in healthy young Chinese adults. PMID: 28064282
- High LEPR expression is associated with aggressive meningiomas. PMID: 26894859
- Genetic variant of LEPR gene rs1137101 is independently related to knee osteoarthritis (OA) susceptibility in Northwest Chinese population with Han ethnicity and may serve as a potential biomarker to determine risk of knee OA. PMID: 27457563
- The leptin receptor SNPs rs1137100 (K109R) and rs1137101 (Q223R) were associated to high sensitivity-C-reactive protein levels at both ages. PMID: 28350535
- systematic review and meta-analysis indicated that the LEPR gene variants (rs6700896, 109G allele, and 109GG genotype) were significantly associated with increased risk of cardiovascular disease (CVD); however, the present study is limited in its small number of included studies, considerable heterogeneity and observational study design PMID: 28368354
- The studied polymorphisms were not associated with gestational diabetes in a Brazilian population. PMID: 28699988
- Leptin receptor Gln223Arg polymorphism does not appear to be related to male fertility. PMID: 27983873
- LEPR polymorphisms are associated with type 2 diabetes risk. [Meta-Analysis] PMID: 27195302
- In 2 unrelated girls with severe obesity, three novel LEPR mutations were detected. Longitudinal growth data show normal childhood growth, and in the older girl, a normal adult height despite hypogonadotropic hypogonadism and the lack of an obvious pubertal growth spurt. PMID: 26925581
- genetic variability in the LEPR gene is associated with idiopathic recurrent spontaneous abortion; more frequent LEPR genotype in patients - rs7516341 (nominal P=0.034, odds ratio [OR] 0.61, 95% confidence interval [CI] 0.38-0.97) and rs1137101 (nominal P=0.048, OR 1.66, 95% CI 1.00-2.80) PMID: 28051281
- our findings suggest that leptin promoted the proliferation, migration and invasion of gallbladder cancer (GBC) cells by increasing OB-Rb expression through the SOCS3/JAK2/p-STAT3 signal pathway. Targeting the leptin/OB-Rb axis could be an attractive therapeutic strategy for treatment of GBC. PMID: 27211817
- genetic association studies in population of children (ages 5-10 years) in Poland: Data suggest that SNPs in LEPR are associated with predisposition to weight loss while engaging in lifestyle modifications for treatment of pediatric obesity in the population studied; carriers of wild-type K665N and at least one minor Q223R allele indicate greatest likelihood of losing weight. PMID: 27240401
- The placental weight ratio exerted a positive effect on the placental mRNA expression of insulin- like growth factor-I and the long isoform of the leptin receptor in malaria-infected pregnant women without fever or chill symptoms. PMID: 28027635
- Data showed that TNF-a and IL-6 polymorphisms were associated with overall and site-specific osteoporosis in both sexes, and that these associations were dependent on rs1805096 and rs1892534 genotypes of LEPR. PMID: 27401061
- this study shows the role of LEPR polymorphisms in the risk of multiple sclerosis and its severity in Iran PMID: 27105071
- Mothers' FTO rs9939609 and LEPR rs1137101 gene polymorphisms presented an impact on birth weight and newborns' BMI, therefore being involved in the newborns' nutritional status and in the design of a potential protocol. PMID: 27930556
- The LEPR rs1805134 polymorphism could be involved in the development of morbid obesity in a Mexican population PMID: 28096764
- Studies reported different mutations in the LEPR have been reported as c.2396-1 G>T, c.1675 G>A, p.P316T related to obesity. [review] PMID: 27313173
- Our meta-analysis suggested a significant association between the LEPR Pro1019Pro polymorphism and T2DM risk PMID: 27657457
- Polymorphism of rs2767485 in leptin receptor(LEPR) gene is associated with the occurrence of adolescent idiopathic scoliosis in the Chinese Han population, suggesting LEPR is a predisposition gene. PMID: 26731704
- Despite the lack of association observed for LEPR Q223R and TNF-alpha G-308A, Indian and Chinese subjects with AA risk genotype for LEPR Q223R/LEP G-2548A and TNF-alpha G-308A/LEP G-2548A, respectively, had increased mean BMI PMID: 24628746
- Here we propose that assessing sOb-R levels in addition to leptin concentrations in breast milk could serve as a valuable tool to investigate effects of the leptin axis in breast milk. PMID: 26804597
- Lys656Asn Polymorphism of Leptin Receptor Gene is associated with Cardiovascular disease. PMID: 25132099
- There is an increase in leptin receptor/leptin ratio in serum from obese rheumatoid arthritis patients compared to non-obese. PMID: 26589684
顯示更多
收起更多
-
相關疾病:Leptin receptor deficiency (LEPRD)
-
亞細胞定位:Cell membrane; Single-pass type I membrane protein. Basolateral cell membrane.; [Isoform E]: Secreted.
-
蛋白家族:Type I cytokine receptor family, Type 2 subfamily
-
組織特異性:Isoform A is expressed in fetal liver and in hematopoietic tissues and choroid plexus. In adults highest expression in heart, liver, small intestine, prostate and ovary. Low level in lung and kidney. Isoform B is highly expressed in hypothalamus, but also
-
數據庫鏈接:
Most popular with customers
-
-
YWHAB Recombinant Monoclonal Antibody
Applications: ELISA, WB, IHC, IF, FC
Species Reactivity: Human, Mouse, Rat
-
Phospho-YAP1 (S127) Recombinant Monoclonal Antibody
Applications: ELISA, WB, IHC
Species Reactivity: Human
-
-
-
-
-